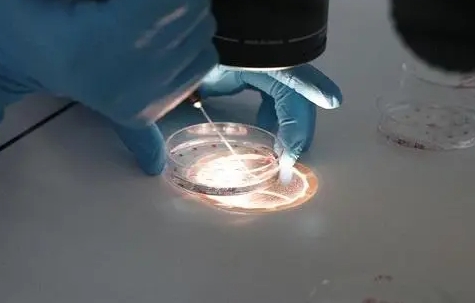

试管婴儿现在不贵了试管婴儿现在做贵不贵随着价格持续上涨,未选择试管婴儿技术的家庭担心由于价格上涨,试管技术的成本会增加。特定的试管婴儿现在很贵吗?担心小编让你详
单身在格鲁吉亚助孕做试管的步骤如下:首先,了解相关法律和政策。格鲁吉亚对单身人士进行试管婴儿助孕有明确的法律规定。单身人士需满足一定的条件,如年龄、婚姻状况等,

帮助怀孕可以增加成功的机会,并怀孕了你的孩子,所以为了使技术顺利进行,你需要做好准备,那么试管婴儿是否已准备好怀孕? 试管婴儿有哪些准备工作?今天,您将熟悉细节

一、泰国三代试管婴儿费用概况近年来泰国三代试管婴儿技术以其较高的成功率以及相对较低的费用,吸引了众多国内家庭。那么去泰国三代试管婴儿多少钱一次呢?泰国三代试管婴
三代试管婴儿技术更是突破了传统试管婴儿技术的局限,可以有效地避免遗传疾病的发生,为更多家庭带来了希望。广州作为名医在线地区的经济中心,拥有众多知名医院,三代试管
原标题:管胚胎植入,子宫内膜厚度好多少?试管婴孩子宫内膜足够厚,可用于胚胎植入。子宫环境是胚胎植入的关键因素。 试管婴儿也是如此。当子宫内膜厚度适中时,此时移植

一、引言在我国,试管婴儿技术为众多不孕不育家庭带来了希望。西安作为一座历史文化名城,拥有多家专业的试管婴儿医院。本文将为您详细介绍西安三家值得了解的试管婴儿医院

泰国饮食中体外的禁忌是什么?原标题:泰国试管饮食中有哪些禁忌?许多在泰国怀孕过试管婴儿的患者经常去看医生。在此期间饮食有哪些限制?你应该注意什么?最重要的是要注
随着科技的不断进步,试管婴儿技术已经成为许多不孕不育夫妇实现生育梦想的希望。美国作为世界上先进的医疗科技国家之一,其人工授精费用备受关注。下面,我们将详细探讨去

一、试管婴儿技术的背景介绍试管婴儿技术,通常被称为辅助生殖技术(ART),是一种在实验室中通过体外受精和胚胎移植等手段,帮助无法自然受孕的夫妇实现生育愿望的科学






